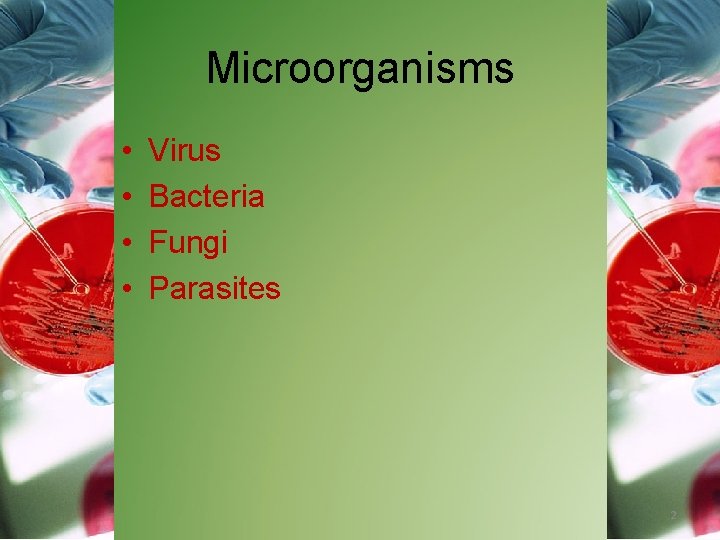
Microorganisms • • Virus Bacteria Fungi Parasites 2

Infection Control Microorganisms Colonization Chain of Infection Breaking

Infection Control Microorganisms Colonization Chain of Infection Breaking the Chain of Infection Common Hospital Infections 1
Microorganisms • • Virus Bacteria Fungi Parasites 2

Microorganisms q. Virus • Cannot be visualized • Contain RNA or DNA, genetic material only • Cannot reproduce without host, need compromised host • Common cold, influenza, mumps, measles, Hep A, B, C, varicella-zoster, AIDs, HPV 3

Microorganisms q. Bacteria • Minute one celled , but no typical nucleus • Classified by shapecocci, bacilli, spirilla • Also by “bunches”-diplo (groups of 2), strepto) chains, staphpylo (clusters of grapes) • GRAM negative= take stain well, thin walled…. easier to clean…. . tuberclerosis is gram positive TB, strep throat, staphpylococcus (wounds), salmonella, Lyme disease, syphilis 4

Microorganisms q. Fungi • Can be one celled (yeasts) or many cells (molds) • Reproduce by spores, need moisture and dark • Difficult to treat • Thrush, black hairy tongue, vulvovaginitis, ringworm (tinea) athlete’s foot (tinea pedis) 5

Microorganisms q. Parasites Complex one celled microbe Able to move or migrate: Two types= protozoa (typically have pseudopod, flagella, cilia and helminths (worms) Common parasites: giardiasis( beaver fever), Trichomonas Vaginalis, malaria, pinworm, trichinosis 6

Types of Colonization • Beneficial Microorganisms – Intestinal flora • Commonly found in intestinal tract, aides in digestion of food – Antibiotics • Made from fungi, bacteria – Fermentation • Wine, cheeses 7

Types of Colonization • Pathogenic Microorganisms – Disease causing- can be singularly disease causing or could be beneficial flora but in different environment where it causes disease. (i. e. E. coli) – Nosocomial-also known as a hospital-acquired infection, develops in patients after a hospital stay, may be bacterial or fungal, and often resistant to antibiotics. Recent studies have shown that nosocomial infections may be linked to healthcare personnel unwittingly spreading infection to susceptible patients – Iatrogenic-Referring to a physical or mental condition caused by a physician or healthcare provider due to exposure to pathogens, toxins or injurious treatment or procedures. 8

infection spread 9

Chain of Infection • • • Infectious agent (host) Reservoir or environment Portal to exit reservoir Means of transmission Portal of entry into new host 10

Breaking the Chain of Infection • Actions: – Method of dress • Hair, jewelry, nail care, clothing – Hand washing • Hand gel • Standard hand washing – Correct Disposal Soiled Items • Sharps container • laundry 11

Breaking the Chain of Infection • Actions: – Hand washing • Single most important means of preventing the spread of infection. • 7 to 8 minutes of washing to remove all the microbes present, depending on the number present. Per JCAHO =at least 20 seconds • Most effective portion of hand washing is the mechanical action of rubbing the hands together. 12

Ignaz Semmelweis, 1815 -1865 • 1840’s: General Hospital of Vienna • Divided into two clinics, alternating admissions every 24 hours: – First Clinic: Doctors and medical students – Second Clinic: Midwives

The Intervention: Hand scrub with chlorinated lime solution Hand hygiene basin at the Lying-In Women’s Hospital in Vienna, 1847. 14

Handwashing 15

When do you wash your hands? • • • When hands are visibly soiled Before and after patient contact After removal of gloves After using the toilet After blowing or wiping the nose Upon leaving an isolation area 16

Self-Reported Factors for Poor Adherence with Hand Hygiene § § § § Handwashing agents cause irritation and dryness Sinks are inconveniently located/lack of sinks Lack of soap and paper towels Too busy/insufficient time Understaffing/overcrowding Patient needs take priority Low risk of acquiring infection from patients Adapted from Pittet D, Infect Control Hosp Epidemiol 2000; 21: 381 -386. 17

Breaking the Chain of Infection • Precautions: – Standard Precautions- Assumes every patient is already infected, incorporates universal precautions and body substance precautions – PPE- personal protective equipment includes gloves, gown, mask, goggles whenever a technologist might come into contact with any body fluids 18

Breaking the Chain of Infection Droplet Precautions Standard Precaution Airborne Precautions Contact Precautions 19

Breaking the Chain of Infection • Precautions: – Disinfection of equipment 20

Super Bug Hospital Infections • MRSA= methicillin-resistant Staphylococcus aureus, usually immuncompromised patient, hospital acquired • C-diff= Clostridium difficile, lives on surfaces a long time, contact precautions needed, result of antibiotic exposure, cases are rising, can’t kill with hand gel, need bleach • VRE= Vancomycin-resistant Enterococci, can be normal flora but when migrates is deadly, Vancomycin used to be used to treat MRSA and C-diff • CRE= carbapenem-resistant Enterobacteriaceae, relatively new, CRE is resistant to antibiotics, and patients who 21

INFECTION CONTROL video 22

Click to add title • Click to add subtitle 23

Click to add title 24
- Slides: 24